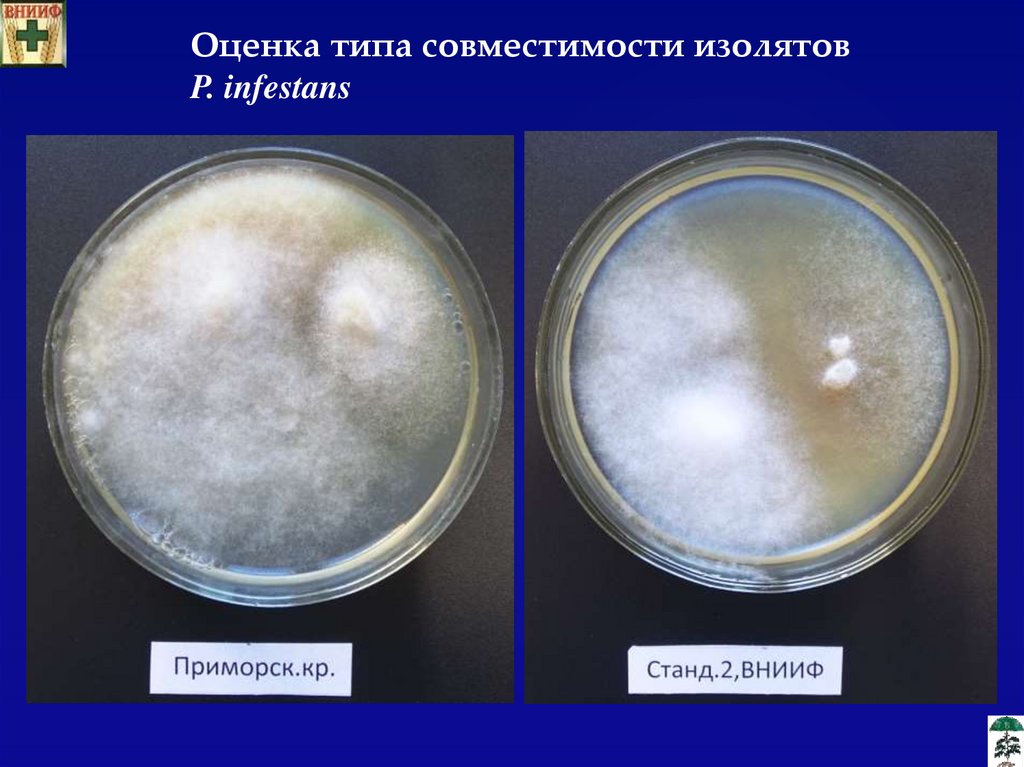

Похожие презентации:
Анализ структуры популяций Phytophthora infestans и особенностей ее развития в Московской области
1.
«Анализ структуры популяций Phytophthorainfestans и особенностей ее развития в
Московской области»
Мельникова В.А., Семенюк И.Н.
Всероссийский НИИ Фитопатологии
2.
По объемам производства картофеля Россия занимаеттретье место в мире (после Китая и Индии) (FAOSTAT, 2014)
3.
Фитофтороз(возб. Phytophthora infestans)
Фитофтороз - одна из наиболее опасных болезней
картофеля в умеренной климатической зоне.
4.
Цель работы :Получить новые знания о структуре популяций
Phytophthora
infestans,
выделенных
в
различных регионах РФ.
5.
Кузнецова МАРазвитие фитофтороза на разных по устойчивости сортах и
гибридах картофеля, ВНИИФ.
6.
Выделение изолятов P. infestans в чистуюкультуру
7.
Анализ структуры популяций P. infestansТип спаривания
(совместимость)
Расовый состав
(вирулентность)
8.
Оценка типа совместимости изолятовP. infestans
9.
Оценка вирулентности изолятов P. infestans10.
Рисунок - Частота отдельных генов вирулентности и фактор вирулентности в картофельной популяции P. infestans, (Московскаяобл., 2019 г.).
11.
Рисунок - Частота отдельных генов вирулентности и фактор вирулентности в картофельной популяции P. infestans,(Новгородская обл., 2019 г.).
12.
Рисунок - Частота отдельных генов вирулентности и фактор вирулентности в картофельной популяции P. infestans,(Ленинградская обл., 2019 г.).
13.
Рисунок–Характеристика картофельных изолятов P.infestans по типу совместимости (Новгородская обл.,
2019 г.).
Рисунок - Характеристика картофельных изолятов P. infestans
по типу совместимости (Ленинградская обл., 2019 г.).
Рисунок - Характеристика картофельных изолятов P.
infestans по типу совместимости (Московская обл., 2019
год).
Рисунок –Характеристика картофельных изолятов P. infestans
по типу совместимости (Смоленская обл., 2019 г.).
14.
Благодарюза внимание!

Промышленность
Промышленность








